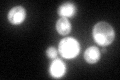
YNR046W
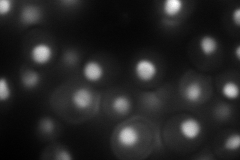
YNR046W
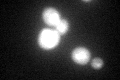
YNR046W
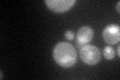
YNR046W

View description
Subunit of tRNA methyltransferase (MTase) complexes in combination with Trm9p and Trm11p; subunit of complex with Mtq2p that methylates Sup45p (eRF1) in the ternary complex eRF1-eRF3-GTP; deletion confers resistance to zymocin
Localization:
Intensity:
Fold change:
Significance:
-
C’ GFP library in SD
nucleus:cytosol111.19 -
N' NOP1pr-GFP in SD

nucleolus143.807 -
N' TEF2pr-mCherry in SD
nucleus,nucleolus194.349 -
N' NATIVEpr-GFP in SD

nucleus,nucleolus103.137 -
N' TEF2pr-VC and Cyto-VN in SD

#N/A0 -
C’ GFP library in SD+DTT
nucleus.cytosol74.310.66No -
C’ GFP library in SD+H2O2

nucleus.cytosol89.890.8No -
C’ GFP library in Starvation Media
nucleus,cytosol91.580.82No -
C’ GFP library on the background of Pup2-DaMP

nucleus:cytosol -
C’ GFP library on the background of CCT mutant

nucleus:cytosol119.2571.07244No
